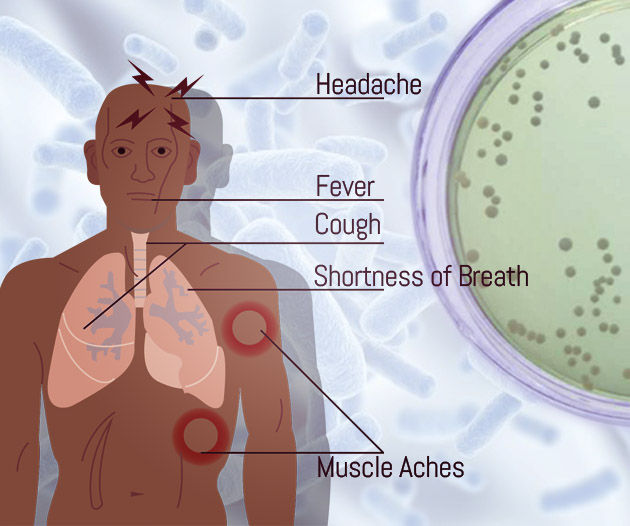

Baktéria, ktorá zabila šéfa Europarlamentu, vyčíňa aj na Slovensku. Zákerná choroba príznakmi pripomína Covid
- Predseda Európskeho parlamentu David Sassoli mal dlhodobé problémy spôsobené baktériami – legionelami
- Baktérie sa nachádzajú v zdrojoch sladkej vody i vo vodovodných systémoch
- Príznaky sú podobné ako pri Covide. Legionárska choroba spôsobená baktériami zabije 1 z 10 nakazených
- Európske centrum pre kontrolu a prevenciu chorôb zaznamenalo nárast ich výskytu v celej Európe i na Slovensku
- Predseda Európskeho parlamentu David Sassoli mal dlhodobé problémy spôsobené baktériami – legionelami
- Baktérie sa nachádzajú v zdrojoch sladkej vody i vo vodovodných systémoch
- Príznaky sú podobné ako pri Covide. Legionárska choroba spôsobená baktériami zabije 1 z 10 nakazených
- Európske centrum pre kontrolu a prevenciu chorôb zaznamenalo nárast ich výskytu v celej Európe i na Slovensku
V utorok svet obletela smutná správa. Vo veku 65 rokov zomrel predseda Európskeho parlamentu (EP) David Sassoli. Hospitalizovaný bol od 26. decembra v nemocnici v Taliansku.
Podľa Deutsche Welle Sassoli zomrel po „vážnych komplikáciách“ v súvislosti s jeho imunitným systémom. The Guardian tvrdí, že zdravotné komplikácie, z ktorých sa Sassoli nikdy nezotavil, nastali po tom, čo sa nakazil baktériami legionelami.
Baktérie mu spôsobili pneumóniu (ťažký zápal pľúc), ktorá býva súčasťou legionárskej choroby. Príznaky choroby sú podobné ako pri Covide.
Českí europoslanci tvrdia, že Sassoli nie je výnimočný prípad. Francúzske sídlo Europarlamentu v Štrasburgu má mať s týmito baktériami problémy celé roky.
V dôsledku výskytu legionel v budove EP dokonca nemá tiecť teplá voda, tvrdí český europoslanec Alexandr Vondra. Ďalší český europoslanec Tomáš Zdechovský tiež potvrdil, že je potrebná rekonštrukcia vodovodného potrubia v budove Parlamentu.
Legionely ale netrápia len Europarlament, čoraz rozšírenejšie sú na celom európskom kontinente, vrátane Slovenska.
Baktéria sa šíri vo vodných systémoch, cez vdýchnutie kvapôčok sa dostane do pľúc
Baktérie legionely (Legionella) sa podľa amerického Centra pre prevenciu a kontrolu chorôb (CDC) vyskytujú prirodzene v sladkovodných zdrojoch, ako sú jazerá alebo potoky. Problémom sa stávajú, keď sa dostanú do vodných systémov, ktoré používa človek.
Baktérie tak môžeme nájsť v sprchových hlaviciach, drezových batériách, ohrievacích či chladiacich zariadeniach, vírivkách, dekoratívnych fontánach a vodných prvkoch i zásobníkoch teplej vody a ohrievačoch.
„Keď sa Legionella rozrastie a rozmnoží vo vodnom systéme budovy, voda obsahujúca Legionellu sa môže šíriť v kvapôčkach dostatočne malých na to, aby ju ľudia mohli dýchať. Ľudia môžu dostať legionársku chorobu alebo Pontiacku horúčku, keď vo vzduchu vdýchnu malé kvapôčky vody, ktoré obsahujú baktérie,“ vysvetľuje CDC prenos baktérií na človeka.

U ľudí, ktorí ochorejú po kontakte baktériami, sa môžu rozvinúť dve rôzne choroby známe ako legionelóza: legionárska choroba a Pontiacka horúčka.
Baktériám sa darí vo vode pri teplote 20 – 45 °C a tiež stojacej vode.
Ďalšou cestou, ale menej obvyklou, je prenos prostredníctvom vdýchnutia pitnej vody s legionelou. Stáva sa to, keď sa voda náhodne dostane do pľúc počas pitia. Ohrozenejší na túto formu sú hlavne ľudia, ktorí majú problém s prehĺtaním.
Vyskytol sa už aj prenos z človeka na človeka, ale CDC ho považuje za mimoriadny.
Baktériu objavili pomerne nedávno
Doteraz je známych 50 druhov legionel a 73 séroskupín, uvádza Margita Špaleková z Ústavu epidemiológie Lekárskej fakulty Univerzity Komenského na webe vydavateľstva Solen.
Baktériu odhalili pomerne nedávno, v roku 1977. Odhaleniu predchádzala veľká epidémia legionárskej choroby na zjazde americkej légie vo Philadelphii (Pensylvánia) v roku 1976. Zjazd sa uskutočnil v Bellevue-Stratford Hotel.
Počas tejto epidémie ochorelo 148 účastníkov zjazdu a 33 osôb, ktoré sa v tom čase nachádzali v blízkosti hotela. Pre 29 z nich skončila choroba úmrtím. Vyšetrovanie ukázalo, že pôvodcom baktérie bola klimatizácia hotela, ktorá obsahovala kontaminovaný aerosól.

Odhalenie baktérií pomohlo objasniť aj iné epidémie pneumónie v minulosti. Tiež ukázalo, že Pontiacku horúčku, ktorej prvý prípad zaznamenali už v roku 1968, spôsobujú legionely.
Pre množstvo ľudí môžu byť baktérie neškodné, prípadne sa u nich môže vyskytnúť len Pontiancka horúčka, s miernymi príznakmi. Niektoré skupiny obyvateľov sú ale ohrozenejšie ako iné. Väčšie riziko je pri ľuďoch vo veku 50 rokov alebo starších, fajčiaroch či bývalých fajčiaroch.
Ohrození sú aj ľudia s chronickými problémami, ľudia so zníženou imunitou či ľudia, ktorí majú cukrovku, problémy s obličkami či pečeňou.
Príznaky ako pri Covide, úmrtnosť môže byť až 40 %
Legionárska choroba je závažnejšou formou a má príznaky podobné chorobe z koronavírusu. Sú nimi: kašeľ, dýchavičnosť, horúčka, bolesť svalov, bolesti hlavy. Možné sú aj iné príznaky, ako je hnačka, nevoľnosť a zmätenosť.
Na liečbu legionárskej choroby sa používajú antibiotiká. Väčšina prípadov tejto choroby sa dá úspešne liečiť, ale aj zdraví ľudia bez iných komplikácií často potrebujú starostlivosť v nemocnici.
Jeden z 10 prípadov končí smrteľne, pričom smrť môže nastať v dôsledku zlyhania pľúc či komplikácií. Pri ľuďoch, čo sa nakazia v zdravotníckom zariadení, je úmrtnosť oveľa väčšia, zomrie asi 1 zo 4,2. Pri pacientoch so zníženou imunitou a pri polymorbídnych pacientoch môže dosiahnuť úmrtnosť až 40 %.
Z legionárskej choroby sa môže vyvinúť aj pneumónia, ktorá je viditeľná na röntgene. Symptómy sa zvyčajne prejavia 2 až 14 dní po vystavení baktériám, ale môže to trvať dlhšie.
Pontiacka horúčka je miernejšia infekcia ako legionárska choroba. Symptómy sú predovšetkým horúčka a bolesti svalov. Príznaky môžu začať medzi niekoľkými hodinami až troma dňami po vystavení baktériám a zvyčajne trvajú menej ako týždeň. Liečba nie je potrebná, ochorenie prejde samo.
V skutočnosti môže byť dvakrát viac prípadov, ako je nahlásených
Legionelóza sa dá diagnostikovať dvoma testami, jedným z moču pacientov, ďalším priamo z hlienu či výplachu pľúc. U nás sa diagnostike venuje Ústav epidemiológie Lekárskej fakulty Univerzity Komenského v Bratislave.
Európske centrum pre kontrolu a prevenciu chorôb (ECDC) zaznamenalo v posledných rokoch nárast prípadov na celom európskom kontinente.
Ročná miera oznámených prípadov sa zvýšila z 1,4 prípadov na 100-tisíc obyvateľov v roku 2015 na 2,2 prípadov na 100-tisíc obyvateľov v roku 2019. Ročne je hlásených 10-tisíc prípadov v Európe, ECDC ale predpokladá, že ich môže byť reálne až dvojnásobok.

Podľa ECDC sa zvýšil aj počet prípadov na Slovensku, kým sme v roku 2015 hlásili 14 prípadov, v roku 2019 to bolo 85.
S baktériami sa dá účinne bojovať niekoľkými prostriedkami, ktoré zahŕňajú ohrev vody na 60 °C, dostatočné chlórovanie a filtrovanie vody. Čistenie sprchových hlavíc či víriviek.
Čítaj viac z kategórie: Zahraničie
Zdroje: Deutsche Welle, TASR, the Guardian, CDC, CDC, Solen, ECDC